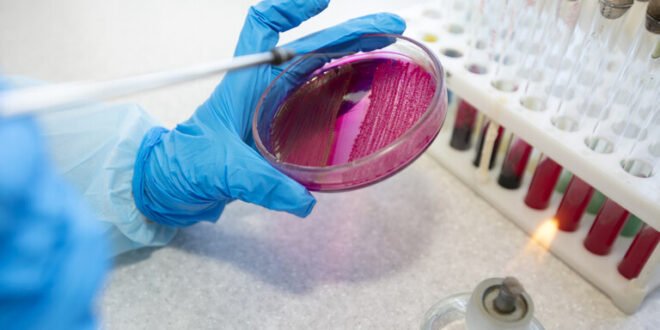

منبر العراق الحر :
أثبتت تجربة سريرية رائدة أن الدواء المستخدم عادة لعلاج ارتفاع نسبة الكوليسترول يمكن أن يقلل بشكل كبير من مستويات “المواد الكيميائية إلى الأبد” (PFAS) في مجرى الدم.
ويفتح هذا الاكتشاف إمكانيات جديدة لعلاج الأفراد المعرضين لهذه المواد الكيميائية الضارة، والتي ترتبط بمجموعة متنوعة من المشكلات الصحية، بما في ذلك السرطان.
لكن الدواء لم يكن مناسبا للاستخدام على نطاق واسع ولفترات طويلة بسبب آثاره الجانبية، وكانت هناك حاجة إلى مزيد من البحث لاستكشاف تأثيره المحتمل على بعض الحالات الصحية المزمنة مثل أمراض الكلى أو نقص المناعة.
وقال مورتن ليندهاردت، وهو طبيب مشارك في التجربة السريرية، لوكالة “فرانس برس” إن التجربة السريرية باستخدام الكوليسترامين (المستخدم لعلاج ارتفاع الكولسترول) أدت إلى خفض مستويات “المواد الكيميائية إلى الأبد” في الدم بنسبة 63%، وهو معدل أكبر بـ 20 مرة مما يتم تحقيقه عادة دون تدخل.
ويوضح الباحثون أن النتائج واعدة لعلاج الأشخاص الذين تعرضوا لجرعات عالية من “المواد الكيميائية إلى الأبد”، والتي يطلق عليها هذا الاسم لأنها تميل إلى التراكم والبقاء في الجسم.
لكن ليندهارت حذر: “لا أعتقد أنه يجب عليك تناول هذا الدواء بشكل دائم بسبب وجود آثار جانبية”.
وأضاف أنه مع ذلك يمكن أن يخفف من “الشعور بالتسمم” الذي قد يشعر به الأشخاص الذين يعانون من مستويات عالية من الملوثات.
ويشير مصطلح “المواد الكيميائية إلى الأبد” (PFAS) إلى الفاعلات بالسطح الفلورية المكونة من نحو 4000 مركب كيميائي.
وعلى الرغم من هذه التحذيرات من الآثار الجانبية المحتملة للكوليسترامين، يعتقد فريق البحث أن الدواء يمكن أن يكون مفيدا بشكل خاص للنساء في سن الإنجاب، ما قد يمنع انتقال “المواد الكيميائية إلى الأبد” إلى الأجنة.
وفي حين أن النتائج واعدة، إلا أن الباحثين يحثون على توخي الحذر وإجراء المزيد من الدراسة لفهم الآثار المترتبة على علاج الكوليسترامين بشكل كامل بالنسبة للتعرض لـ “المواد الكيميائية إلى الأبد”.
المصدر: ميديكال إكسبريس
 منبر العراق الحر منبر العراق الحر
منبر العراق الحر منبر العراق الحر